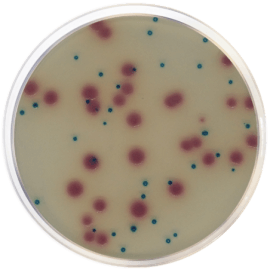
ESBL CHROMOGENIC MEDIUM 500 grams/bottle

Close
-
-
ACETAMIDE BROTH BASE (UNE-EN 12780, EN ISO 16266) 500 grams/bottle Brand: CONDALAB SKU: CDL/1155Ask for Price
-
-
-
-
-
BRYANT & BURKEY BASE BROTH (modified with resarzurine) 500 grams/bottle Brand: CONDALAB SKU: CDL/1247Ask for Price
-
-
-
-
LISTERIA ENRICHMENT BROTH BASE FRASER (ISO 11290-1) 500 grams/bottle Brand: CONDALAB SKU: CDL/1120Ask for Price
-

Validate your login